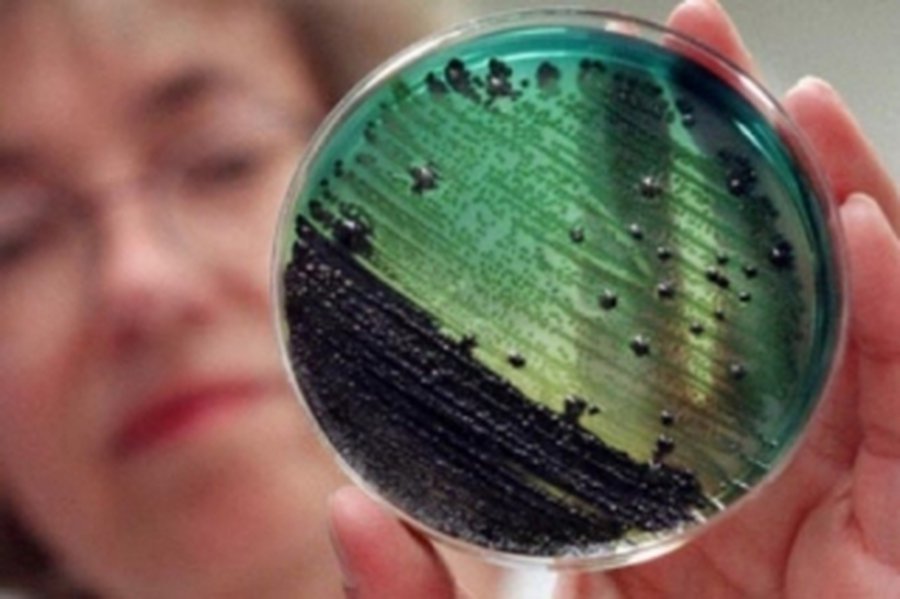
Осторожно: Пищевые заразные заболевания                                                                                                                - В Висагинасе

О заболеваниях, которые могут передаваться от животного к человеку, напоминает Висагинское отделение государственной ветеринарно-пищевой службы. :::Читать далее здесь.
Осторожно: Пищевые заразные заболевания
Комментарии
Для комментирования необходимо войти в аккаунт Facebook (Meta)
В Висагинасе
другие новости раздела →
За сутки в детское отделение Висагинской больницы поступили девять детей с рвотой и высокой температурой

Памятка для жителей «Воздушная опасность. Что важно знать и как действовать?»

Выставка работ Олега Удовенко к 90-летию со дня рождения художника

«Fotofabrikas»: фотовыставка в необычном месте с необычным ракурсом (видео)

Бесплатные автобусы – не только по Висагинасу и в садовые общества, но и на Белое озеро

Купальный сезон: безопасный отдых у водоёмов

В Висагинасе будут установлены велостоянки контейнерного типа и другие
